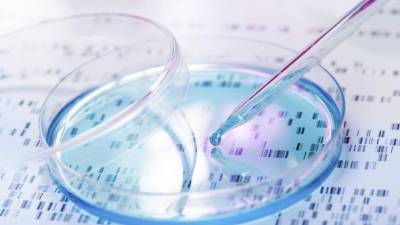
Unos niveles más altos de ADN tumoral se vinculaban con unas perspectivas de la enfermedad generalmente peores.

Estados Unidos
El consumo de marihuana podría aumentar el riesgo de un fallo raro y temporal del músculo cardiaco que puede sentirse como un ataque cardiaco en toda regla, sugiere un nuevo estudio.
Las personas que consumían marihuana tenían casi el doble de riesgo que los no consumidores de sufrir un ataque de cardiomiopatía por estrés, una afección también conocida como takotsubo, señaló el coautor del estudio, el doctor Amitoj Singh, miembro jefe de cardiología de la Red de Salud de la Universidad de St. Luke en Bethlehem, Pensilvania.
Además, los consumidores de marihuana que experimentaron un takotsubo eran más propensos a sufrir un paro cardiaco o a necesitar la implantación de un desfibrilador que los no consumidores que sufrieron un takotsubo, dijo Singh. El paro cardiaco sucede cuando el corazón de repente deja de latir.
'La marihuana no parece ser del todo segura, como plantean algunos de los defensores de la marihuana', dijo Singh. Pero el estudio no probó que la marihuana provoque el takotsubo.
Singh presentó sus hallazgos el domingo en la reunión anual de la Asociación Americana del Corazón (American Heart Association), en Nueva Orleáns. Las investigaciones presentadas en las reuniones se consideran preliminares hasta que se publican en una revista revisada por profesionales.
Una vocera de la Asociación Americana del Corazón cuestionó los hallazgos, anotando que el estudio se enfocó sobre todo en el consumo de marihuana entre personas que se habían enfermado de takotsubo, que es una afección muy poco común.
'Creo que están llegando a conclusiones que van más allá de los datos', dijo Donna Arnett, decana y profesora de epidemiología del Colegio de Salud Pública de la Universidad de Kentucky, en Lexington. 'Estos datos solo sugieren. No creo que se puedan ampliar para decir que no se debe consumir marihuana debido al riesgo de cardiomiopatía por estrés'.
El takotsubo es una debilidad repentina y usualmente temporal del músculo cardiaco que reduce la capacidad del corazón de bombear, en esencia un 'aturdimiento' del corazón, explicó Singh. Puede provocar dolor de pecho, falta de aire, mareo y a veces desmayo.
Por lo general, la afección no provoca efectos a largo plazo en la salud del corazón de la persona, señaló Singh.
El takotsubo por lo general afecta a las mujeres mayores, y se ha vinculado con la ansiedad o el estrés, comentó Singh.
Singh dijo que él y sus colaboradores decidieron investigar el tema tras tratar a un paciente en su hospital que había ingerido marihuana, y que se descubrió que sufría un takotsubo.
Los investigadores analizaron datos de una base de datos de salud federal, identificando a más de 33,000 personas que habían sido hospitalizadas con cardiomiopatía por estrés entre 2003 y 2011 en Estados Unidos.
De esos pacientes, también se identificó a 210 como consumidores de marihuana, el equivalente a menos de un 1 por ciento de todas las personas identificadas con un takotsubo.
Los consumidores de marihuana con un takotsubo eran más propensos a ser más jóvenes y de sexo masculino, con pocos factores de riesgo cardiaco adicionales, encontraron los investigadores.
'La mayoría de las personas que consumieron marihuana y desarrollaron un takotsubo fueron hombres jóvenes, algo diametralmente opuesto a lo que se sabe del takotsubo', dijo Singh.
A pesar de su edad y salud cardiaca relativa, los consumidores de marihuana fueron significativamente más propensos que los no consumidores a entrar en paro cardiaco (un 2.4 frente a un 0.8 por ciento, respectivamente) y a necesitar la implantación de un desfibrilador para detectar y corregir unos ritmos cardiacos peligrosamente anómalos (un 2.4 frente a un 0.6 por ciento, respectivamente).
'No deberían tener estos efectos secundarios graves, como el paro cardiaco', dijo Singh. 'Es algo alarmante para las personas que consumieron marihuana'.
Al observar la base de datos completa, Singh y sus colaboradores concluyeron que el consumo activo de marihuana duplica el riesgo de takotsubo en los hombres jóvenes.
Se sabe que las sustancias que hay en la marihuana interactúan con los sistemas que controlan o moderan las hormonas del estrés en el cuerpo, una posible explicación de esta observación, planteó Singh.
Paul Armentano, subdirector de NORML, un grupo que defiende la reforma de las leyes sobre la marihuana, dijo que el takotsubo es extremadamente raro, y que ocurrió en bastante menos del 1 por ciento de los pacientes seguidos por la base de datos de atención de la salud.
Por otro lado, los datos nacionales indican que más del 10 por ciento de los estadounidenses consumen marihuana, y hasta un tercio de los adultos jóvenes de 18 a 25 años son consumidores, señaló Armentano.
'Es obvio que si el consumo de cannabis es un factor de riesgo de esta afección, es un factor de riesgo casi insignificante', enfatizó.
El consumo de marihuana podría aumentar el riesgo de un fallo raro y temporal del músculo cardiaco que puede sentirse como un ataque cardiaco en toda regla, sugiere un nuevo estudio.
Las personas que consumían marihuana tenían casi el doble de riesgo que los no consumidores de sufrir un ataque de cardiomiopatía por estrés, una afección también conocida como takotsubo, señaló el coautor del estudio, el doctor Amitoj Singh, miembro jefe de cardiología de la Red de Salud de la Universidad de St. Luke en Bethlehem, Pensilvania.
Además, los consumidores de marihuana que experimentaron un takotsubo eran más propensos a sufrir un paro cardiaco o a necesitar la implantación de un desfibrilador que los no consumidores que sufrieron un takotsubo, dijo Singh. El paro cardiaco sucede cuando el corazón de repente deja de latir.
'La marihuana no parece ser del todo segura, como plantean algunos de los defensores de la marihuana', dijo Singh. Pero el estudio no probó que la marihuana provoque el takotsubo.
Singh presentó sus hallazgos el domingo en la reunión anual de la Asociación Americana del Corazón (American Heart Association), en Nueva Orleáns. Las investigaciones presentadas en las reuniones se consideran preliminares hasta que se publican en una revista revisada por profesionales.
Una vocera de la Asociación Americana del Corazón cuestionó los hallazgos, anotando que el estudio se enfocó sobre todo en el consumo de marihuana entre personas que se habían enfermado de takotsubo, que es una afección muy poco común.
'Creo que están llegando a conclusiones que van más allá de los datos', dijo Donna Arnett, decana y profesora de epidemiología del Colegio de Salud Pública de la Universidad de Kentucky, en Lexington. 'Estos datos solo sugieren. No creo que se puedan ampliar para decir que no se debe consumir marihuana debido al riesgo de cardiomiopatía por estrés'.
El takotsubo es una debilidad repentina y usualmente temporal del músculo cardiaco que reduce la capacidad del corazón de bombear, en esencia un 'aturdimiento' del corazón, explicó Singh. Puede provocar dolor de pecho, falta de aire, mareo y a veces desmayo.
Por lo general, la afección no provoca efectos a largo plazo en la salud del corazón de la persona, señaló Singh.
El takotsubo por lo general afecta a las mujeres mayores, y se ha vinculado con la ansiedad o el estrés, comentó Singh.
Singh dijo que él y sus colaboradores decidieron investigar el tema tras tratar a un paciente en su hospital que había ingerido marihuana, y que se descubrió que sufría un takotsubo.
Los investigadores analizaron datos de una base de datos de salud federal, identificando a más de 33,000 personas que habían sido hospitalizadas con cardiomiopatía por estrés entre 2003 y 2011 en Estados Unidos.
De esos pacientes, también se identificó a 210 como consumidores de marihuana, el equivalente a menos de un 1 por ciento de todas las personas identificadas con un takotsubo.
Los consumidores de marihuana con un takotsubo eran más propensos a ser más jóvenes y de sexo masculino, con pocos factores de riesgo cardiaco adicionales, encontraron los investigadores.
'La mayoría de las personas que consumieron marihuana y desarrollaron un takotsubo fueron hombres jóvenes, algo diametralmente opuesto a lo que se sabe del takotsubo', dijo Singh.
A pesar de su edad y salud cardiaca relativa, los consumidores de marihuana fueron significativamente más propensos que los no consumidores a entrar en paro cardiaco (un 2.4 frente a un 0.8 por ciento, respectivamente) y a necesitar la implantación de un desfibrilador para detectar y corregir unos ritmos cardiacos peligrosamente anómalos (un 2.4 frente a un 0.6 por ciento, respectivamente).
'No deberían tener estos efectos secundarios graves, como el paro cardiaco', dijo Singh. 'Es algo alarmante para las personas que consumieron marihuana'.
Al observar la base de datos completa, Singh y sus colaboradores concluyeron que el consumo activo de marihuana duplica el riesgo de takotsubo en los hombres jóvenes.
Se sabe que las sustancias que hay en la marihuana interactúan con los sistemas que controlan o moderan las hormonas del estrés en el cuerpo, una posible explicación de esta observación, planteó Singh.
Paul Armentano, subdirector de NORML, un grupo que defiende la reforma de las leyes sobre la marihuana, dijo que el takotsubo es extremadamente raro, y que ocurrió en bastante menos del 1 por ciento de los pacientes seguidos por la base de datos de atención de la salud.
Por otro lado, los datos nacionales indican que más del 10 por ciento de los estadounidenses consumen marihuana, y hasta un tercio de los adultos jóvenes de 18 a 25 años son consumidores, señaló Armentano.
'Es obvio que si el consumo de cannabis es un factor de riesgo de esta afección, es un factor de riesgo casi insignificante', enfatizó.